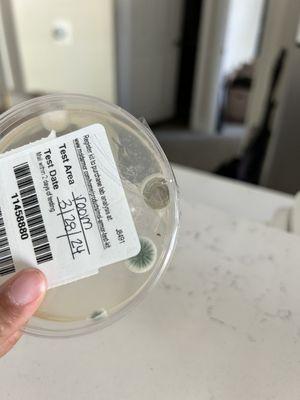
Diamonte On Bell

Real Estate Property Management
3022 W Juniper Ave
Phoenix, AZ 85053
Real Estate Property Management located in the vibrant city of Phoenix AZ specializes in providing comprehensive property management services. With a focus on maximizing property value and ensuring tenant satisfaction the company offers tailored solutions for residential and commercial real estate owners. Their experienced team is dedicated to maintaining properties efficiently and effectively making them a trusted partner in the local real estate market.
Generated from this place's information
Also at this address
See a problem?
You might also like
Partial Data by Infogroup (c) 2025. All rights reserved.